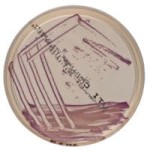
Brilliance_UTI_Clarity_Agar_pożywka_gotowa_do_oznaczania_patogenów_dróg_moczowych_Bestlabs.jpg
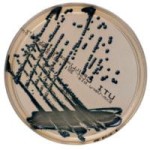
Brilliance_UTI_Clarity_Agar_pożywka_gotowa_do_oznaczania_patogenów_dróg_moczowych_Argenta.jpg
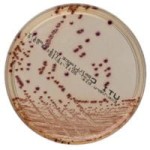
Brilliance_UTI_Clarity_Agar_pożywka_gotowa_Bestlabs.jpg
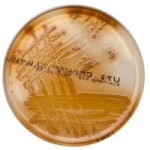
Brilliance_UTI_Clarity_Agar_pożywka_gotowa_Argenta.jpg

Brilliance UTI Clarity Agar pożywka gotowa do oznaczania patogenów dróg moczowych
• Opakowanie: 10 szt.
• Płytka: 90 mm.
• Podłoże chromogenne.
• Do oznaczania patogenów dróg moczowych.
• Wyrób medyczny: Tak.
 Opis
Opis
Brilliance UTI Clarity Agar to innowacyjne podłoże chromogenne, zaprojektowane do oznaczania i różnicowania patogenów dróg moczowych. Dzięki unikalnej formule, pożywka umożliwia identyfikację kluczowych drobnoustrojów odpowiedzialnych za infekcje układu moczowego, takich jak Escherichia coli, Staphylococcus saprophyticus, enterokoki, czy gatunki z rodzajów Proteus, Morganella i Providencia.
Specyfikacja techniczna
- Opakowanie: Zawiera 10 gotowych do użycia płytek.
- Rozmiar płytki: Standardowe 90 mm, ułatwiające analizę w laboratorium.
- Typ podłoża: Chromogenne, do wizualnego różnicowania patogenów.
Cechy i zalety Brilliance UTI Clarity Agar
Zaawansowane różnicowanie patogenów
- Kolonie różowo-czerwone: Powstają w wyniku aktywności β-galaktozydazy, charakterystycznej dla bakterii Escherichia coli i Staphylococcus saprophyticus.
- Kolonie niebiesko-turkusowe: Wynik aktywności β-glukozydazy enterokoków.
- Kolonie ciemnoniebieskie/fioletowe: Wskazują obecność bakterii z grupy coli, wykazujących aktywność obu enzymów.
- Brązowa aureola: Otacza kolonie bakterii z rodzajów Proteus, Morganella i Providencia, dzięki aktywności deaminazy tryptofanu.
Gotowość do użycia
- Eliminuje konieczność czasochłonnego przygotowywania pożywki w laboratorium.
- Standaryzowane parametry zapewniają spójność i powtarzalność wyników.
Wszechstronność zastosowania
- Idealna do badań diagnostycznych w laboratoriach mikrobiologicznych zajmujących się analizą próbek moczu.
- Znajduje zastosowanie w medycynie, badaniach środowiskowych i diagnostyce weterynaryjnej.
Dlaczego warto wybrać Brilliance UTI Clarity Agar?
Dokładna diagnostyka
Dzięki wykorzystaniu aktywności enzymatycznej bakterii, pożywka pozwala na szybką i precyzyjną identyfikację najczęstszych patogenów dróg moczowych.
Skrócenie czasu analizy
Chromogenne wskaźniki umożliwiają wizualne różnicowanie mikroorganizmów już po krótkim czasie inkubacji, co przyspiesza proces diagnostyczny.
Zgodność z normami jakości
Produkt spełnia wymagania najwyższych standardów mikrobiologicznych, zapewniając niezawodność w codziennej pracy laboratoryjnej.
Zastosowanie Brilliance UTI Clarity Agar
Diagnostyka infekcji układu moczowego
Podłoże jest przeznaczone do oznaczania patogenów odpowiedzialnych za infekcje dróg moczowych, takich jak zapalenie pęcherza, odmiedniczkowe zapalenie nerek, czy inne zakażenia urologiczne.
Laboratoria diagnostyczne i kliniczne
Brilliance UTI Clarity Agar znajduje zastosowanie w badaniach przesiewowych próbek moczu oraz w różnicowaniu patogenów w celu dobrania optymalnej terapii.
__________________________________________________________________________________________________________________________________________________________________________________________
Jest to wyrób medyczny.
Wyrób medyczny przeznaczony wyłącznie do użytku profesjonalnego, zgodnie z definicją zawartą w art. 2 pkt 1.26 Ustawy o wyrobach medycznych. Produkty te nie są przeznaczone do stosowania w warunkach domowych. Zakupu mogą dokonać jedynie osoby posiadające Prawo Wykonywania Zawodu (PWZ) lub firmy, podając numer NIP podczas składania zamówienia. W przypadku zamówienia złożonego przez użytkownika domowego, zostanie ono anulowane, a ewentualna wpłata zwrócona na konto klienta.
__________________________________________________________________________________________________________________________________________________________________________________________
W powyższym linku znajdą Państwo bazę aktualnych certyfikatów firmy OXOID. Wystarczy wpisać numer LOT zamówionej przez Państwa partii, w celu uzyskania odpowiedniego certyfikatu.
 Koszty dostawy
Cena netto, nie zawiera podatku
Koszty dostawy
Cena netto, nie zawiera podatku
darmowa i wygodna wysyłka
już od 800 zł netto
Najwyższa jakość
produktów potwierdzona certyfikatami
Zakupy 24h na dobę
wygodne i bezpieczne
bezpłatna konsultacja
z ekspertem online